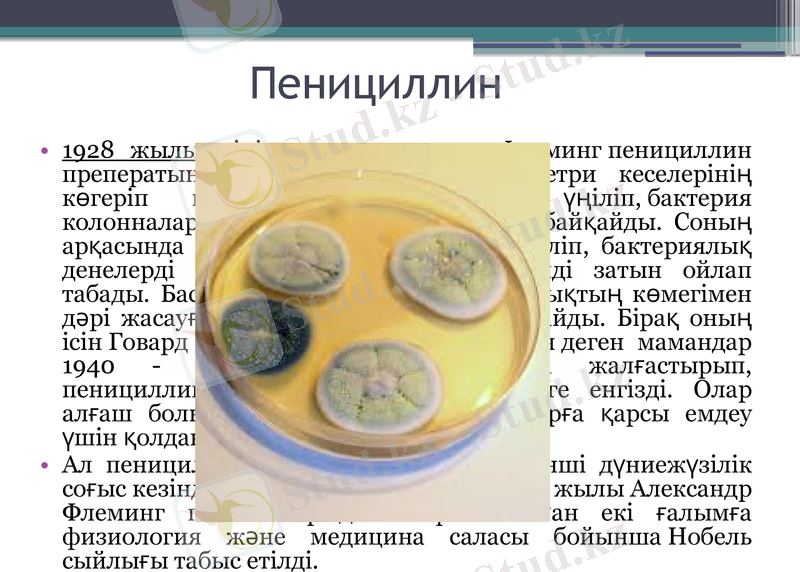
Slide 13

Химия және фармация саласындағы ірі ашулар мен олардың өзара байланысы



Химия және фармация салаларында бірқатар ашулар жасаған оқымыстылар мен фармацевтер.

Жоспар
Кіріспе
Химия және фармациия саласы
Фармация жән химияның байланысы
Химия және фармация саласындағы ұлы ашылулар
Мочевина
Менделеев кестесі
Атом теориясы
Фармация саласы бойынша ашылулар
Витамин
Инсулин
Пенициллин
Антибиотик
Индикатор
Қорытынды

Кіріспе
Ғылым (араб. : علم (ілім) - білім, тану; лат. scientia - білім) - ақиқат жайлы объективті білімдерді жетілдіру мен жүйелеуге бағытталған адам іс-әрекетінің саласы. Жалпы мағынасы: жүйелік білім мен тәжірибе. Арнайы мағынасы - ғылым жолмен жинақталған білім жүйесі, сонымен қатар зерттеумен келген ретті білім жинағы.

Химия - заттарды айналып өзгеруін зерт тейтін жаратылыстану ғылымдарының бірі.
Фармация (грек. pharmakeіa - дәрі, дәріні қолдану) - денсаулық сақтау ісінің халыққа дәрімен көмек көрсетуді іске асыратын бір саласы. Фармация өсімдік пен жануардан алынатын шикізаттар, оларды алғаш рет өңдеу кезінде алынатын өнімдер туралы ғылым

Фармация және химияның байланысы
Фармацевтикалық химия - химия ғылымдарының жалпы заңдарына негізделген дәрілік заттардың құрылымы, физикалық және химиялық қасиеттері, олардың химиялық құрылымы мен дененің әрекеті арасындағы өзара қарым-қатынас, сапаны бақылау әдістері және сақтау кезінде пайда болған өзгерістерді зерттейді.

Химия саласындағы ұлы ашылулар
Оттектің ашылынуы
Пристли ең алғашында жаңа қарапайым затты ашқандығын түсінбеді, ол ауаның құрамдас бөлшектерінің бірін бөліп көрсеттім деп есептеді (және бұл газды «дефлогистацияланған ауа» деп атады) . Өзінің жаңалығы туралы Пристли көрнекі француз химигі Антуан Лавуазьеге жеткізді. 1775 жылы А. Лавуазье оттегінің ауаның құрамдас бір бөлігі болып табылатындығын, қышқыл және көптеген заттардың бар екендігін орнатты.
Джозеф Пристли

Мочевинаның ашылуы
Фридрих Веллер ойламаған жерденорганикалық емес заттан мочевинаны синтездеп шығарады. Тірі емес заттардан тірі заттардың шыға алатынын дәлелдеді. 1828 жылға дейін органикалық заттар тек тірі организмдерден ғана алынады деп есептелінген.
Фридрих Веллер

Менделеев кестесінің ашлуы
1869 жылы 63 элемент атомдық массасы бойынша өсу ретімен орналастырып, элементтердің қасиеті таблицалық циклмен сәйкес жасалыған. Ал бо тұрған орындарда әлі ашылмаған элементтердің тұратындығын болжап айтқан.

Атом теориясы
Aтом мен молекула түсініктеріне нақты анықтама беріліп, атом-молекулалык ілімнің негізі 1860 жылы қаланған. Германияның Карлсруэ қаласында химиктердің халықаралық съезінде осы ілім қабылданды.
Джон Дальтон

Жалпы:
Радиоактивтілік
Электроэнеригияның химиялық заттарды өзгерке ұшыратаныны туралы
Электрон
Химиялық байланыстағы электрондар
Пластмасса

Фармация саласындағы ашылулар
Витаминдердің ашылуы
Дәрумен - адам мен жануарлардың тіршілігіне, олардың ағзасындағы зат алмасудың бірқалыпты болуы үшін аз мөлшерде өте қажетті биологиялық активті органикалық қоспалар. Дәрумен (латынша vіta - тіршілік және амин) туралы ілімнің негізін 1880 жылы орыс дәрігері Николай Лунин салды. 1912 жылы поляк дәрігері Казимеж Функ сол кезге дейін жасалған тәжірибелер нәтижесін қорытындылап, ғылымға дәрумен терминін енгізді. Дәрумен немесе витамин - салыстырмалы құрылысы күрделі емес және әртүрлы табиғаты бар төменгі молекулярлы органикалық қосылыстардың тобы.

Инсулин
1869 жылы Берлинде медик студент П. Лангерганс микроскоппен ұйқы безін зерттеуде бұрын соңды болмаған топтар құрып орналасқан клеткалар тобын көрді. Ұйқы безін Лангерганс клеткалары синтездейді, гормон организмде көмірсу алмасуын реттейді, глюкозаны сіңіруін қамтамасыз етеді. Инсулиннің 1-ші препараттары 1922 жылдан бастап шығарылды. Шошқадан немесе бұқаның инсулині қолданылды
Пенициллин
1928 жылы өзінің «салақтығынан», Флеминг пенициллин преператының негізін қалады. Ол Петри кеселерінің көгеріп кеткен біреуінің ішіне үңіліп, бактерия колонналарының мөлдір күйге енгенін байқайды. Соның арқасында ғылымға үлкен жаңалық әкеліп, бактериялық денелерді бұзатын пенициллин белсенді затын ойлап табады. Бастапқыда ол өзі ашқан жаңалықтың көмегімен дәрі жасауға болатынына аса сене қоймайды. Бірақ оның ісін Говард Флори мен Эрнст Борис Чейн деген мамандар 1940 - 1941 жылдар аралығында жалғастырып, пенициллинді тазалау әдісін тәжірибеге енгізді. Олар алғаш болып бактериялық инфекцияларға қарсы емдеу үшін қолданған.
- Іс жүргізу
- Автоматтандыру, Техника
- Алғашқы әскери дайындық
- Астрономия
- Ауыл шаруашылығы
- Банк ісі
- Бизнесті бағалау
- Биология
- Бухгалтерлік іс
- Валеология
- Ветеринария
- География
- Геология, Геофизика, Геодезия
- Дін
- Ет, сүт, шарап өнімдері
- Жалпы тарих
- Жер кадастрі, Жылжымайтын мүлік
- Журналистика
- Информатика
- Кеден ісі
- Маркетинг
- Математика, Геометрия
- Медицина
- Мемлекеттік басқару
- Менеджмент
- Мұнай, Газ
- Мұрағат ісі
- Мәдениеттану
- ОБЖ (Основы безопасности жизнедеятельности)
- Педагогика
- Полиграфия
- Психология
- Салық
- Саясаттану
- Сақтандыру
- Сертификаттау, стандарттау
- Социология, Демография
- Спорт
- Статистика
- Тілтану, Филология
- Тарихи тұлғалар
- Тау-кен ісі
- Транспорт
- Туризм
- Физика
- Философия
- Халықаралық қатынастар
- Химия
- Экология, Қоршаған ортаны қорғау
- Экономика
- Экономикалық география
- Электротехника
- Қазақстан тарихы
- Қаржы
- Құрылыс
- Құқық, Криминалистика
- Әдебиет
- Өнер, музыка
- Өнеркәсіп, Өндіріс
Қазақ тілінде жазылған рефераттар, курстық жұмыстар, дипломдық жұмыстар бойынша біздің қор #1 болып табылады.



Ақпарат
Қосымша
Email: info@stud.kz